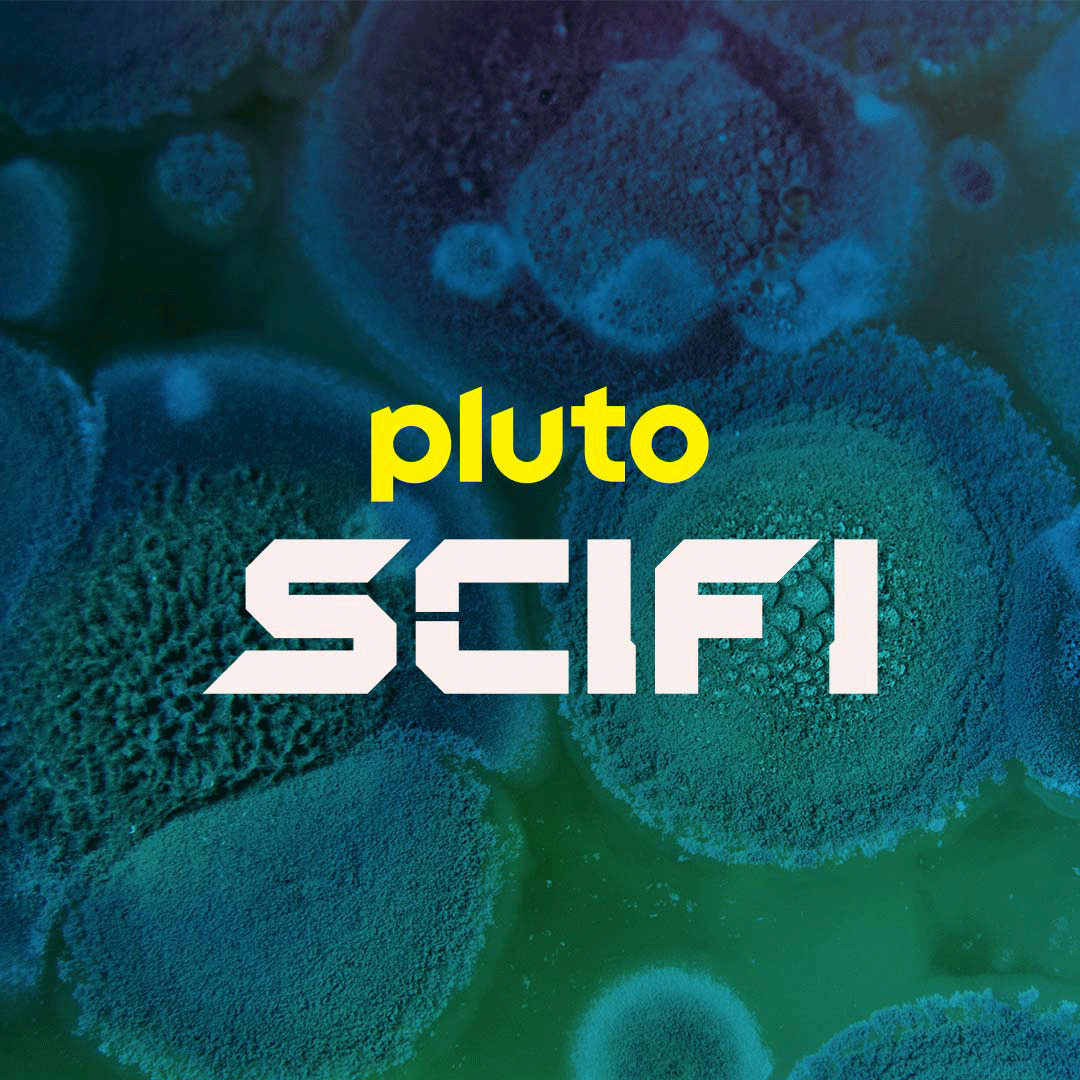
Paramount Press Express Pluto TV Paramount Press Express Pluto TV

Are you a sci-fi fanatic looking for new shows to binge-watch? Look no further than Pluto TV Sci-Fi! This channel offers a wide range of science fiction series and movies for you to enjoy, all for free. Say goodbye to endless scrolling through streaming services and hello to Pluto TV Sci-Fi!
With Pluto TV Sci-Fi, you can immerse yourself in captivating storylines, mind-bending plots, and futuristic worlds right from the comfort of your own couch. Whether you’re a fan of classic sci-fi or prefer the latest releases, there’s something for everyone on Pluto TV Sci-Fi. Get ready to embark on an intergalactic adventure like never before!

pluto tv sci fi
Discover the Best of Pluto TV Sci-Fi
From cult classics to hidden gems, Pluto TV Sci-Fi has it all. Tune in to explore new galaxies, encounter alien species, and unravel the mysteries of the universe. With a diverse selection of shows and movies, you’ll never run out of thrilling content to watch on Pluto TV Sci-Fi.
Featuring both beloved favorites and exciting new releases, Pluto TV Sci-Fi offers hours of entertainment for sci-fi enthusiasts of all ages. Whether you’re into space operas, dystopian futures, or time travel escapades, Pluto TV Sci-Fi has something that will transport you to another dimension.
So grab your popcorn, get cozy on the couch, and prepare to be transported to worlds beyond your imagination with Pluto TV Sci-Fi. With endless possibilities and unlimited excitement, Pluto TV Sci-Fi is your go-to destination for all things science fiction. Don’t miss out on the adventure – start watching Pluto TV Sci-Fi today!

Pluto TV Sci Fi Ansehen Live TV Sender Kostenlos Pluto TV
Paramount Press Express Pluto TV

Watch Pluto TV Sci Fi Live TV Channel For Free Pluto TV

Watch Pluto TV Sci Fi Live TV Channel For Free Pluto TV